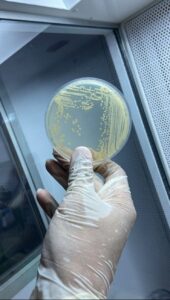

Vencedor do 20º Prêmio FAPEMA 2025, o estudo mostra que substância é estratégica contra a resistência antimicrobiana

José Lima

Doutorando em Ciências da Saúde (UFMA), graduado em Farmácia pela UFMA e Faculdade de Farmácia da Universidade do Porto (FFUP)-Portugal, mestre em Ciências da Saúde pela UFMA e especialista em Microbiótica e Sistema Imunológico Humano pelo Instituto Líbano.
VENCEDOR DO PRÊMIO FAPEMA 2025
Categoria: Dissertação de Mestrado
Área de conhecimento: Ciências Biológicas
Título: Atividade Antibacteriana da Silibina contra Microrganismos de Interesse Clínico
Orientador: Valério Monteiro Neto
Coorientador: Rafael Cardoso Carvalho
A resistência antimicrobiana-RAM é considerada uma ameaça global e crescente. Estimativas indicam que, até 2050, cerca de 10 milhões de mortes por ano poderão ser atribuídas a infecções causadas por microrganismos resistentes. Número que gera um alerta, pois, pode superar o câncer como principal causa de mortalidade no mundo. Esse cenário também se reflete no Brasil, onde UTIs-Unidade de Terapia Intensiva registraram, entre 2012 e 2023, aumento de infecções associadas à assistência à saúde por bactérias multirresistentes.
É deste tema que trata a dissertação de mestrado do pesquisador José Lima Pereira Filho, da Universidade Federal do Maranhão (UFMA), campus São Luís. O trabalho, intitulado ‘Atividade Antibacteriana da Silibina contra Microrganismos de Interesse Clínico’, investiga o potencial de um composto natural no combate a bactérias multirresistentes, um dos maiores desafios atuais da saúde pública. A pesquisa teve a orientação do doutor em Ciências e professor da UFMA, Valério Monteiro Neto, e coorientação do professor Rafael Cardoso Carvalho.
Diante da escassez de novos antibióticos no mercado, a pesquisa aposta na silibina, um composto natural bioativo, como alternativa terapêutica. O objetivo geral do estudo foi avaliar, por meio de análises in silico e in vitro, o potencial antibacteriano da silibina contra microrganismos de interesse clínico, além de investigar sua interação com antibióticos de uso convencional.
A metodologia envolveu testes laboratoriais rigorosos, incluindo a determinação da concentração inibitória e bactericida mínima, avaliação de sinergia com antibióticos como ciprofloxacina, oxacilina e vancomicina, além de ensaios de citotoxicidade e hemólise. Também foram realizados estudos de erradicação de biofilmes e modelagens computacionais para identificar possíveis alvos bacterianos da silibina.
Os resultados demonstraram que a silibina apresenta atividade antimicrobiana, ação antivirulência e efeito sinérgico com antibióticos convencionais, especialmente contra linhagens de Staphylococcus aureus. “Esses achados abrem novas perspectivas para o desenvolvimento de terapias mais eficazes, capazes de potencializar medicamentos já disponíveis”, afirma José Lima.
Um dos aspectos mais inovadores da dissertação foi a investigação do efeito da silibina sobre a produção de estafiloxantina, pigmento associado à virulência do MRSA. “Pela primeira vez no Maranhão, aplicamos a técnica de inibição da estafiloxantina para avaliar o impacto de um composto natural sobre esse fator de virulência”, destaca o pesquisador. O pigmento ajuda a bactéria a resistir ao estresse oxidativo e à ação de antibióticos.

Patógenos
Entre os patógenos de maior preocupação estão Staphylococcus aureus, Pseudomonas aeruginosa e Enterococcus faecalis. De acordo com a Organização Mundial da Saúde (OMS), estas bactérias integram a lista de microrganismos prioritários para o desenvolvimento de novos antibióticos. O destaque vai para o Staphylococcus aureus, resistente à meticilina-MRSA, associado a altas taxas de mortalidade, internações prolongadas e elevados custos hospitalares.
“O MRSA é especialmente preocupante porque reúne resistência a múltiplos antibióticos e fatores de virulência que dificultam o tratamento, como a formação de biofilmes e a produção de estafiloxantina”, explica José Filho. Segundo ele, essas características tornam as infecções mais persistentes e aumentam o risco de desfechos graves, como bacteremias e endocardites.
Combate a bactérias
Além da relevância científica, o estudo dialoga diretamente com o desenvolvimento regional. A pesquisa está alinhada às diretrizes do Plano Estratégico Maranhão 2050, ao priorizar inovação em saúde, valorização da ciência local e busca por soluções terapêuticas adaptadas às necessidades do estado. A abordagem integrada fortalece a capacidade científica e tecnológica regional, além de criar bases para futuras aplicações clínicas.
Ele também destaca a conquista do Prêmio FAPEMA como um importante resultado do trabalho e que mostra a relevância da pesquisa científica para soluções em diversas áreas, a exemplo da saúde. “A pesquisa abre perspectivas para desenvolvimento de terapias mais eficazes e que potencializem medicamentos já disponíveis”, afirmou José Lima.






